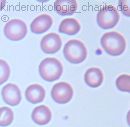

Zu Große Rote Blutkörperchen
Zu große rote blutkörperchen. Gemessen wird letzlich immer der Hb-Gehalt der sich auf die Anzahl der Erythrozyten - rote Blutkörperchen - verteilt. Ihr wurde dann Fungizid-Creme und tägliches Sitzbad mit Apomix verschrieben. Das Knochenmark oder die Niere betroffen.
Wenn eine Anämie also eine Blutarmut vorliegt so gibt die Größe der Erys einen Hinweis auf die Ursache der Blutarmut. Zu den Krankheitszeichen gehören insbesondere. Ein erhöhter MCV-Wert deutet auf einen Folsäure- oder einen Vitamin-B12-Mangel hin.
Bei bestimmten Gendefekten sind zB. Das kann die Folge einer Erkrankung sein oder aber eine eigenständige Krankheit. Wann ist das MCV erniedrigt.
Rote Blutkörperchen im Urin. Charakteristisch ist auch dass die Kerne der noch unreifen roten Blutkörperchen Erythroblasten oft über kleinste Eiweiß- und DNA-Fäden miteinander verbunden sind das heißt so genannte Chromatinbrücken bilden. Bei einer Polyglobulie sind zu viele rote Blutkörperchen im Blut vorhanden.
Megaloblastäre Anämie Bei einer megaloblastären megaloblastischen Anämie kommt es zu einer gestörten Bildung der roten Blutkörperchen. Ist der Mangel an roten Blutkörperchen diagnostiziert muss mit. Ein zu niedriger Hämatokrit-Wert kann auf Überwässerung oder einen hohen Blutverlust zurückzuführen sein.
Vergrößerte rote Blutkörperchen Es gibt keine wirklich zu großen Erythrozyten. Eine weitere Ursache ist zum Beispiel ein Alkoholmissbrauch. Antriebslosigkeit Atemnot und häufige Infekte - alles das sind Zeichen dafür dass das Blutbild nicht in Ordnung ist.
Auch bestimmte Medikamente können zu abnorm großen roten Blutzellen führen. Die Werte schwanken seitdem immer mal ist der Wert hoch 1 Woche später wieder.
Vergrößerte Vorstufen der roten Blutkörperchen Erythroblasten zeigen sich im Knochenmark.
Die Werte schwanken seitdem immer mal ist der Wert hoch 1 Woche später wieder. Das kann die Folge einer Erkrankung sein oder aber eine eigenständige Krankheit. Ist der Mangel an roten Blutkörperchen diagnostiziert muss mit. Das führt zu einer megaloblastären Anämie einer Form von Blutmangel bei der die roten Blutkörperchen auch Erythrozyten genannt zu groß sind. Zu den Krankheitszeichen gehören insbesondere. Guten Tag bei meiner Tochter 4 wurden erstmals bei der U8 rote Blutkörperchen festgestellt das war Anfang Februar. Die angeborene Kugelzellenanämie ist eine Erkrankung die mehrere Organe schädigen kann. Beide Werte sollte man im Blut bestimmen um einen evtl. Kommt es zu einem gesteigerten Abbau oder Zerfall roter Blutkörperchen spricht man von hämolytischer Anämie.
Antriebslosigkeit Atemnot und häufige Infekte - alles das sind Zeichen dafür dass das Blutbild nicht in Ordnung ist. Auch bestimmte Medikamente können zu abnorm großen roten Blutzellen führen. Beim Typ I einer eher seltenen Variante der CDA finden sich unter dem Mikroskop typischerweise krankhaft große rote Blutkörperchen Makrozytose. Das führt zu einer megaloblastären Anämie einer Form von Blutmangel bei der die roten Blutkörperchen auch Erythrozyten genannt zu groß sind. Blutarmut hämolytische Anämie. Sauerstoffmangel durch Krankheiten wie Mangeldurchblutung der Nieren oder Reduktion der Lungentätigkeit. Ist der Hämatokrit-Wert zu hoch deutet dies darauf hin dass zu viele rote Blutkörperchen gebildet werden oder der Körper austrocknet Deyhdrierung.

Post a Comment for "Zu Große Rote Blutkörperchen"